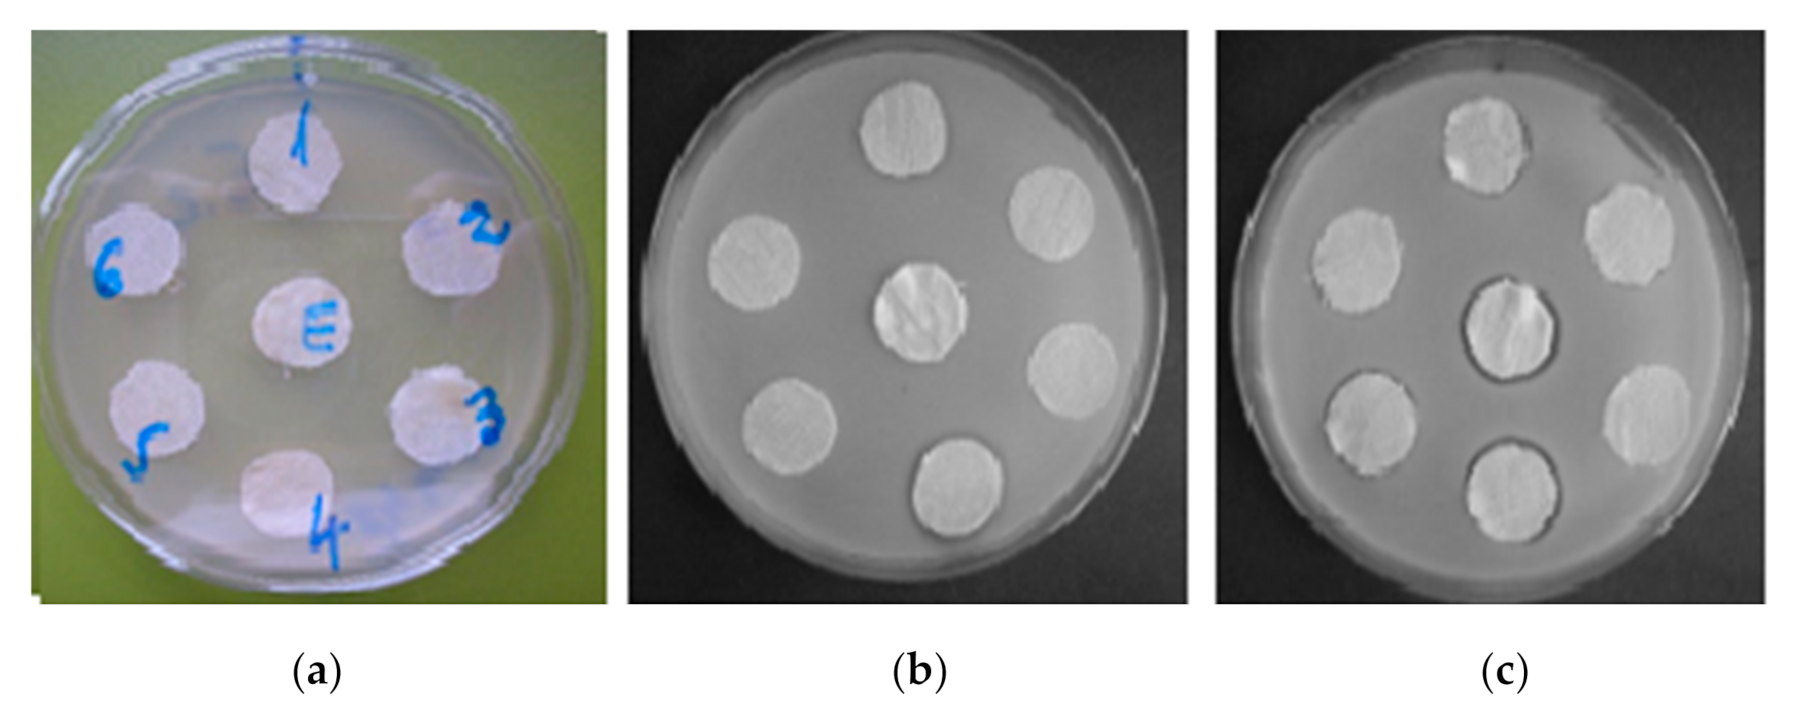
Polymers 13 00410 g011 Polymers 13 00410 g011

Multifunctional Finishing of Cotton with Compounds Derived from MCT-β-CD and Quantification of Effects Using MLR Statistical Analysis
Abstract
1. Introduction
- Wrinkle-free, antibacterial, flame retardant and antioxidant properties on linen fabrics due to a finishing with chitosan-citric acid and phytic acid-thiourea [2];
- Wrinkle-free, antibacterial, flame retardant, UV protection and antioxidant properties using layer-by-layer finishing with chitosan, sodium lignin sulphonate and boric acid [3];
- Biocidal and hydrophobic properties when the cotton fabrics were modified with difunctional polysiloxanes [4];
- Water repellence, flame retardance and antibacterial properties through deposition of three-dimensional tetrakis (hydroxymethyl) phosphonium chloride-urea polymer coating [5];
- Crease resistance in addition with the antimicrobial effects on knitted fabric using dimethylol dihydroxy ethylene urea (DMDHEU) and titanium dioxide (TiO2) [6].
- Water repellent, stain repellent, shrink resistance and quick dry properties using fluorocarbon resin [7];
- Wrinkle recovery, antibacterial effect, ultraviolet protection, bending rigidity and antistatic properties using butanetetracarboxylic acid and zinc oxide nanoparticles [8];
- Biocompatibility with durable antibacterial properties using ZnO nanoparticles and gallic acid [9];
- Flame retardance, antibacterial and water repellence effects were obtained via a chemical foam application method [10];
- Coloration, antioxidant and antimicrobial effects on cotton fabrics using pomegranate peel extract and silver nanoparticles synthesized by a green biochemical reduction method [11];
- Fireproof, anti-soil, oleophobization and anti-crease effects using a mixture of phosphorus compound, a perfluorinated resin and melamine compound [12];
- Antibacterial activity, electrical conductivity, superhydrophobicity, catalytic activity, ultraviolet blocking and coloration properties using N-(2-ethylhexyl) carbamate aqueous solution, followed by microwave-assisted reduction of silver ions (Ag+) on the fibrous cotton surface [13].
2. Materials and Methods
2.1. Statistical Analysis
2.2. Proton Nuclear Magnetic Resonance (1H-NMR)
2.3. Fourier Transform Infrared Spectroscopy (FTIR)
2.4. Scanning Electron Microscopy (SEM) and Energy Dispersive X-ray Spectroscopy (EDAX)
2.5. X-ray Diffraction Analysis (XRD)
2.6. Wrinkle Recovery Angles (WRAs)
2.7. Water Absorption Capacity
2.8. Differential Scanning Calorimetry (DSC)
2.9. Integrity of Textile Support
2.10. Quality Index, IC
2.11. Antibacterial Capacity
3. Results and Discussion
3.1. Synthesis and Characterization of D-CD
- Glyoxal was chosen to confer good wrinkle recovery capacity to the cotton, because glyoxal has high reactivity and high polymerization capacity [17,49,50]. Glyoxal has a high capacity to react with water, giving reactions of hydration, oligomerization and disproportionation [26,27,51,52,53,54,55]. Glyoxal solution is a mixture between the non-hydrated form (glyoxal in the form of CHO-CHO, of trans-type) and the hydrated forms of monohydrate and dihydrate types (gem-diol, dimer and trimer) (Table S1).
- MCT-β-CD is a multifunctional compound that could form ether links with cellulose from cotton fabric [58,59,60]. Due to the big number of OH groups disposed to the outside of the truncated cone form, and to the large volume occupied by MCT-β-CD and D-CD respectively, the treated cotton is expected to have good absorption of aqueous solutions.
- Mixing the volume of glyoxal with that of ED in a Berzelius beaker (according to data in Table 1 and Table 2) and stirring for 30 min. This step leads to the generation of imines/Schiff base; it is known that a glyoxal solution is a mixture of monomer (M), monohydrated (MH) and dehydrated (DH) forms. In this step, only M and MH can react with ED, as in Scheme 1.
- Adding NaOH (as catalyst, up to pH = 12) in the same Berzelius beaker where the Schiff base was obtained; after vigorous stirring (30 min), the MCT-β-CD solution was added (according to the data in Table 1 and Table 2) and the stirring was continued for 30 min at room temperature to allow the N-alkylation reactions to take place, with the formation of the D-CDs compounds.
- The presence of the Schiff base was confirmed by the disappearance of the absorption band specific to C=O from glyoxal of monomer type (at 1727 cm−1), as the result of transformation of this group in C=N. The absorption band for C=N appears at 1644 cm−1 (Figure 2a) [65]. However, ED, being a bifunctional compound, has two NH2 groups, of which only some are converted to C=N groups, and others remain non-involved in this chemical reaction. This fact was confirmed by the peaks from 3416–3413 cm−1 (NH2 asymmetric and symmetric), 1644 cm−1 (N–ppH bend overlapped on C=N) and 1073 cm−1 (C-N stretch).
- The presence of some absorption bands specific to primary amines on the spectrum of D-CD (D14, Figure 2b) was confirmed by NH2 in-plane bend from 1637 cm−1 and two NH2 stretchings (asymmetric and symmetric) at 3478 and 3417 cm−1 (overlapped on OH stretching derived from glyoxal and MCT-β-CD). This fact proved the presence of NH2 groups non-involved in chemical interaction between the intermediate compound (Schiff base) and MCT-β-CD. These groups conferred good antibacterial capacity to cotton treated with D14 or with any D-CD synthetized in this work.
- The presence of MCT-β-CD in the final treatment agent (Figure 2b) was hard to notice, because the weak absorption band from 1530 cm−1, specific for C=N from triazine cycle, was covered by the large absorption band C=N from Schiff base (at 1644 cm−1) [32,66,67,68]; this fact is evident only when the spectra were overlapped.
3.2. Interaction of D-CD with Cellulose
3.3. Characterization of Multifunctional Cotton
3.3.1. Fourier Transform Infrared Spectroscopy (FTIR)
3.3.2. Scanning Electron Microscopy (SEM)
3.3.3. Energy Dispersive X-ray Spectroscopy (EDAX)
3.3.4. X-ray Diffraction Analysis (XRD)
3.4. Quantification Effects with MLR Analysis
3.4.1. WRA for Dry and Wet Samples
3.4.2. Water Absorption Capacity
3.4.3. Differential Scanning Calorimetry (DSC)
3.5. Influence of Treatment Conditions on the Textile Material Integrity
3.6. Antibacterial Capacity
- The type and structure of the microorganisms used for testing (different composition and ultrastructure of the cell wall of the two species).
- The component of the multifunctional agent (D-CD) reflected by the proportions of the three agents (glyoxal, ED and MCT-β-CD) used in its synthesis. This aspect determined the differentiation between the antibacterial behavior against Micrococcus luteus of the samples functionalized with D-CDs: (a) The specimens/samples S4 and S8 that differed only by the content of MCT-β-CD (higher in sample S8) led to diameters of inhibition zones of 16 mm on S4 and 19 mm on S8). (b) The S12 sample was functionalized with a richer D-CD compound in ED and strongly inhibited the growth of Micrococcus luteus colonies (19 mm for the diameter of inhibition zone) when compared to the S11 sample (16 mm).
- Applying or not applying additional treatment for antibacterial protection (with AgNO3).
- Number of washing cycles after functionalization, respectively, after the functionalization treatment + AgNO3.
4. Conclusions
Supplementary Materials
Author Contributions
Funding
Institutional Review Board Statement
Informed Consent Statement
Data Availability Statement
Acknowledgments
Conflicts of Interest
References
- Popescu, V. Multifunctionalizations of textile materials highlighted by unconventional dyeings. In Frontiers of Textile Materials: Polymers, Nanomaterials, Enzymes, and Advanced Modification Techniques; Shabbir, M., Ahmed, S., Sheikh, J.S., Eds.; Scrivener Publishing LLC: Beverly, MA, USA, 2020; pp. 219–290. [Google Scholar]
- Sheikh, J.; Bramhecha, I. Multifunctional modification of linen fabric using chitosan based formulations. Int. J. Biol. Macromol. 2018, 118, 896–902. [Google Scholar] [CrossRef] [PubMed]
- Safi, K.; Kant, K.; Bramhecha, I.; Mathur, P.; Sheikh, J. Multifunctional modification of cotton using layer-by-layer finishing with chitosan, sodium lignin sulphonate and boric acid. Int. J. Biol. Macromol. 2020, 158, 903–910. [Google Scholar] [CrossRef] [PubMed]
- Przybylak, M.; Maciejewski, H.; Dudkiewicz, A.; Walentowska, J.; Flaczyk, F.J. Development of multifunctional cotton fabrics using difunctional polysiloxanes. Cellulose 2018, 25, 1483–1497. [Google Scholar] [CrossRef]
- Ahmed, M.T.; Morshed, M.N.; Farjana, S.; An, S.K. Fabrication of new multifunctional cotton-modal-recycled aramid blended protective textiles through deposition of 3D-polymer coating: High fire retardant, water repellent and antibacterial property. New J. Chem. 2020, 44, 12122–12133. [Google Scholar] [CrossRef]
- Sela, S.K.; Hossain, N.A.K.M.; Rakib, M.S.I.; Niloy, M.K.H. Improving the functionality of raw cotton: Simultaneous strength increases and additional multi-functional properties. Heliyon 2020, 6. [Google Scholar] [CrossRef]
- Jain, A.K.; Tesema, A.F.; Haile, A. Development of multifunctional cotton using fluorocarbon resin. J. Text. Fibrous Mater. 2018, 1, 1–8. [Google Scholar] [CrossRef]
- Aslam, S.; Hussain, T.; Ashraf, M.; Tabassum, M.; Rehman, A.; Iqbal, K.; Javid, A. Multifunctional finishing of cotton fabric. AUTEX Res. J. 2019, 19, 191–200. [Google Scholar] [CrossRef]
- Salat, M.; Petkova, P.; Hoyo, J.; Perelshtein, I.; Gedanken, A.; Tzanov, T. Durable antimicrobial cotton textiles coated sonochemically with ZnO nanoparticles embedded in an in-situ enzymatically generated bioadhesive. Carbohydr. Polym. 2018, 189, 198–203. [Google Scholar] [CrossRef]
- Basyigit, Z.O.; Kut, D.; Hauser, P. Development of multifunctional cotton fabric via chemical foam application method. Text. Res. J. 2020, 90, 991–1001. [Google Scholar] [CrossRef]
- Islam, S.; Butola, B.S.; Gupta, A.; Roy, A. Multifunctional finishing of cellulosic fabric via facile, rapid in-situ green synthesis of AgNPs using pomegranate peel extract biomolecules. Sustain. Chem. Pharm. 2019, 12. [Google Scholar] [CrossRef]
- Popescu, V.; Manole, D.; Ciobanu, L. Multi-functional finishing for cotton materials. World J. Text. Eng. Technol. 2020, 6, 72–88. [Google Scholar]
- Atta, A.M.; Abomelka, H.M. Multifunctional finishing of cotton fibers using silver nanoparticles via microwave-assisted reduction of silver alkylcarbamate. Mater. Chem. Phys. 2021, 260. [Google Scholar] [CrossRef]
- Courtenay, J.C.; Deneke, C.; Lanzoni, E.M.; Costa, C.A.; Bae, Y.; Scott, J.L.; Sharma, R.I. Modulating cell response on cellulose surfaces; tunable attachment and scaffold mechanics. Cellulose 2018, 25, 925–940. [Google Scholar] [CrossRef] [PubMed]
- Choi, H.; Kim, J.H.; Shin, S. Characterization of cotton fabrics treated with glyoxal and glutaraldehyde. J. Appl. Polym. Sci. 1999, 73, 2691–2699. [Google Scholar] [CrossRef]
- Frick, J.G., Jr.; Harper, R.J., Jr. Finishing agents for cotton from acrylamide and dialdehyde. Text. Res. J. 1983, 53, 758–762. [Google Scholar] [CrossRef]
- Schramm, C.; Rinderer, B. Nonformaldehyde durable press finishing of cotton fabric: Quantitative evaluation of cellulose bound glyoxal. Text. Res. J. 2002, 72, 357–360. [Google Scholar] [CrossRef]
- Welch, C.M.; Danna, G.F. Glyoxal as a non-nitrogenous formaldehyde-free durable-press reagent for cotton. Text. Res. J. 1982, 52, 149–157. [Google Scholar] [CrossRef]
- Welch, C.M. Glyoxal as a formaldehyde-free durable press reagent for mild curing applications. Text. Res. J. 1983, 53, 181–186. [Google Scholar] [CrossRef]
- Kittinaovarat, S.; Kantuptim, P.; Singhaboonponb, T. Wrinkle resistant properties and antimicrobial efficacy of cotton fabrics treated with glyoxal system and with combination of glyoxal and chitosan system. J. Appl. Polym. Sci. 2006, 100, 1372–1377. [Google Scholar] [CrossRef]
- Laga, S.K.; Wasif, A.I. A combination of glyoxal and glycol as an ecofriendly crosslinking agent for cotton. Res. J. Text. Apparel. 2013, 17, 41–50. [Google Scholar] [CrossRef]
- Lee, E.S.; Kim, S.I. Effect of additives on durable-press cotton fabrics treated with a glyoxal/glycol mixture. J. Appl. Polym. Sci. 2005, 96, 975–978. [Google Scholar] [CrossRef]
- Yang, Q.; Dou, F.; Liang, B.; Shen, Q. Studies of cross-linking reaction on chitosan fiber with glyoxal. Carbohydr. Polym. 2005, 59, 205–210. [Google Scholar] [CrossRef]
- Chitwood, H.C.; Namce, R.W. Piperazino-Piperazines. U.S. Patent 2345237A, 28 March 1944. [Google Scholar]
- Edwards, G.M.; Weiss, U.; Gillardi, R.D.; Karle, I.L. Formation of a heterocyclic cage compound from ethylenediamine and glyoxal. Chem. Commun. 1968, 24, 1649–1650. [Google Scholar] [CrossRef]
- Mattioda, G.; Blanc, A. Glyoxal. Ullmann’s Encyclopedia of Industrial Chemistry, 5th ed.; Elvers, B., Hawkins, S., Ravenscroft, M., Rounsaville, J.F., Schultz, G., Eds.; VCH Publishers: NY, USA, 1989; Volume 12, pp. 83–87. [Google Scholar]
- Gupta, N.; Naaz, R.; Nigam, G.D. Water mediated condensation reaction of aldehydes and amines. Int. J. Pharma Bio Sci. 2010, 1, 224–226. [Google Scholar]
- Irie, Y.; Koga, Y.; Matsumoto, T.; Matsubara, K. o-Amine-assisted Cannizzaro reaction of glyoxal with new 2,6-diaminoanilines. Eur. J. Org. Chem. 2009, 14, 2243–2250. [Google Scholar] [CrossRef]
- Pankaj, D. Glyoxal: A techno-commercial profile. Chem. Wkly. 2007, 217–223. [Google Scholar]
- Yimer, A.M. Chemical synthesis, spectral characterization and antimicrobial studies on complexes of Ni(II), Cu(II) and Zn(II) with N, N-di (o-hydroxybenzenoylmethylene) ethylenediamine. Am. J. BioSci. 2014, 2, 22–34. [Google Scholar]
- Sabzalian, Z.; Alam, M.N.; Ven, T.G.M. Hydrophobization and characterization of internallycrosslink-reinforced cellulose fibers. Cellulose 2014, 21, 1381–1393. [Google Scholar]
- Medronho, B.; Andrade, R.; Vivod, V.; Ostlund, A.; Miguel, M.G.; Lindman, B.; Voncina, B.; Valente, A.J.M. Cyclodextrin-grafted cellulose: Physico-chemical characterization. Carbohydr. Polym. 2013, 93, 324–330. [Google Scholar] [CrossRef]
- Popescu, V.; Vasluianu, E.; Popescu, G. Quantitative analysis of the multifunctional finishing of cotton fabric with non-formaldehyde agents. Carbohydr. Polym. 2014, 111, 870–882. [Google Scholar] [CrossRef]
- Wacker-Chemie GmbH. Technical Information Sheet CAVATEX W7 MCT; Wacker-Chemie GmbH: Burghausen, Germany, 2003. [Google Scholar]
- Szejtli, J. Cyclodextrins and their Inclusion Complexes; Akademiai Kiado: Budapest, Hungary, 1982. [Google Scholar]
- Szejtli, J. Introduction and general overview of cyclodextrin chemistry. Chem. Rev. 1998, 98, 1743–1754. [Google Scholar] [CrossRef]
- Szejtli, J. Utilization of cyclodextrins in industrial products and processes. J. Mater. Chem. 1997, 7, 575–587. [Google Scholar] [CrossRef]
- Saenger, W.; Steiner, T. Cyclodextrin inclusion complexes: Host-guest interactions and hydrogen-bonding networks. Acta Cryst. 1998, 54, 798–805. [Google Scholar] [CrossRef]
- Brown, S.H. Multiple linear regression analysis: A matrix approach with MATLAB. Ala. J. Math. 2009, 34, 1–3. [Google Scholar]
- Popescu, G. Numerical Resolvings in MATLAB; TehnoPress: Iasi, Romania, 2009. [Google Scholar]
- Parthibana, M.; Thilagavathi, G. Optimisation of process parameters for coloration and antibacterial finishing of wool fabric using natural fungal extract. Indian J. Fibre Text. Res. 2012, 37, 257–264. [Google Scholar]
- Smith, V.K. A note on Student’s t test in multiple regression. J. Financ. Quant. Anal. 1971, 6, 1053–1056. [Google Scholar] [CrossRef]
- Jamshidian, M.; Jennrich, R.I.; Liu, W. A study of partial F tests for multiple linear regression models. Comput. Stat. Data Anal. 2007, 51, 6269–6284. [Google Scholar] [CrossRef]
- Ahvenainen, P.; Kontro, I.; Svedstrom, K. Comparison of sample crystallinity determination methods by X-ray diffraction for challenging cellulose I materials. Cellulose 2016, 23, 1073–1086. [Google Scholar] [CrossRef]
- Ciolacu, D.; Ciolacu, F.; Popa, V.I. Amorphous cellulose–structure and characterization. Cell. Chem. Technol. 2011, 45, 13–21. [Google Scholar]
- Iliescu, E. Technology for Bleaching and Aperture of Textile Materials; Rotaprint: Iasi, Romania, 1981. [Google Scholar]
- Popescu, V. Technology for Preparation and Finishing of Textiles; Tehnopress: Iasi, Romania, 2014. [Google Scholar]
- Popescu, V.; Muresan, A.; Popescu, G.; Balan, M.; Dobromir, M. Ethyl chitosan synthesis and quantification of the effects acquired after grafting it on a cotton fabric, using ANOVA statistical analysis. Carbohydr. Polym. 2016, 138, 94–105. [Google Scholar] [CrossRef]
- Schramm, C.; Rinderer, B. Determination of cotton-bound glyoxal via an internal Cannizzaro reaction by means of high-performance liquid chromatography. Anal. Chem. 2000, 72, 5829–5833. [Google Scholar] [CrossRef] [PubMed]
- Popescu, V.; Sandu, I.C.A.; Popescu, G. Study of cotton grafting with hemiacetal-MCT-β-CD derivative using Fourier Transform infrared spectroscopy and statistical analysis. Rev. Chim. 2017, 68, 2055–2059. [Google Scholar] [CrossRef]
- Alar, V.; Juraga, I.; Runje, B.; Alar, Z. Influence of glyoxal on localized corrosion of austenitic stainless steel in spring water. Mater. Werkst. 2009, 40, 910–912. [Google Scholar] [CrossRef]
- Fratzke, A.R., Jr. Kinetic Analysis of the Dimerization and Disproportionation of Aqueous Glyoxal. Ph.D. Thesis, Iowa State University, Ames, IA, USA, 1985. [Google Scholar]
- Fratzke, A.R.; Reilly, P.J. Kinetic analysis of the disproportionation of aqueous glyoxal. Int. J. Chem. Kinet. 1986, 18, 757–773. [Google Scholar] [CrossRef]
- Kielhorn, J.; Michel, P.C.; Schmidt, S.; Mangelsdorf, I. Glyoxal. Concise International Chemical Assessment Document 57; World Health Organization: Geneva, Switzerland, 2004. [Google Scholar]
- Popescu, V.; Popescu, G.; Sandu, I.C.A. Highlighting a Cotton Grafting Process Using the Spectral Subtraction Method and Statistical Analysis. Rev. Chim. 2017, 68, 1884–1889. [Google Scholar] [CrossRef]
- Clayden, J.; Greeves, N.; Warren, S.; Wothers, P. Organic Chemistry, 1st ed.; University Press: Oxford, UK, 2000; Chapters 6, 12 and 14. [Google Scholar]
- Nenitescu, C.D. Organic Chemistry; Didactic and Pedagogic Editure: Bucharest, Romania, 1980. [Google Scholar]
- Grigoriu, A.; Popescu, O. Applications of cyclodextrines in textiles—A review. Bull. Polyt. Inst. Iasi 2011, 11, 94–101. [Google Scholar]
- Popescu, V.; Sandu, I.C.A.; Popescu, G. FTIR analysis for studying the possibility of grafting onto cotton of some compounds resulted from the interaction of carbonyl compounds with monochlorotriazinyl-β-cyclodextrin. Rev. Chim. 2016, 67, 2184–2189. [Google Scholar]
- Popescu, V.; Sandu, I. Multifunctional finishing with tetrol and monochlortriazinil β-cyclodextrine. Rev. Chim. 2014, 65, 811–818. [Google Scholar]
- Kliegman, J.M.; Barnes, R.K. Glyoxal derivatives. II. Reaction of glyoxal with aromatic primary amines. J. Org. Chem. 1970, 35, 3140–3143. [Google Scholar] [CrossRef]
- Yu, G.; Bayer, A.R.; Galloway, M.M.; Korshavn, K.J.; Fry, C.G.; Keutsch, F.N. Glyoxal in aqueous ammonium sulfate solutions: Products, kinetics and hydration effects. Environ. Sci. Technol. 2011, 45, 6336–6342. [Google Scholar] [CrossRef]
- Thirunarayanan, G. Synthesis, IR and NMR spectral correlations in some symmetrical diimines. Bull. Chem. Soc. Ethiop. 2014, 28, 73–79. [Google Scholar] [CrossRef]
- Issa, R.M.; Khedr, A.M.; Rizk, H. 1H NMR, IR and UV/VIS spectroscopic studies of some Schiff bases derived from 2-aminobenzothiazole and 2-amino-3-hydroxypyridine. J. Chin. Chem. Soc. 2008, 55, 875–884. [Google Scholar] [CrossRef]
- Lal, S.; Arora, S.; Sharma, C. Synthesis, thermal and antimicrobial studies of some Schiff bases of chitosan. J. Therm. Anal. Calorim. 2016, 124, 909–916. [Google Scholar] [CrossRef]
- Avram, M.; Mateescu, G. Infrared Spectroscopy. Applications in Organic Chemistry; Technical Editure: Bucharest, Romania, 1988. [Google Scholar]
- Derrick, M.R.; Stulik, D.; Landry, J.M. Infrared Spectroscopy in Conservation Science; The Getty Conservation Institute: Los Angeles, CA, USA, 1999. [Google Scholar]
- Fouda, M.M.G.; Fahmy, H.M. Multifunctional finish and cotton cellulose fabric. Carbohydr. Polym. 2011, 86, 625–629. [Google Scholar] [CrossRef]
- Naji, A.A.; Bahjat, A.S.; Sadiq, M.H.I. Theoretical molecular structure determination infrared frequencies with solvent effect of some α-diketones. J. Basrah Res. 2011, 37, 93–99. [Google Scholar]
- Avzianova, E.; Brooks, S.D. Raman spectroscopy of glyoxal oligomers in aqueous solutions. Spectrochim. Acta A Mol. Biomol. Spectrosc. 2013, 101, 40–48. [Google Scholar] [CrossRef]
- Manohar, S.N. FTIR Spectroscopic Studies of Atmospheric Molecules in Ice and on Ice Surfaces. Master’s Thesis, University of Bremen, Bremen, Germany, 2008. [Google Scholar]
- Sosa, M.J.; Vinkovic, M.; Topic, V.D. NMR Spectroscopy of 2-hydroxy-1-naphthylidene Schiff bases with chloro and hydroxy substituted aniline moiety. Croat. Chem. Acta. 2006, 79, 489–495. [Google Scholar]
- Wang, F.; Tanaka, R.; Cai, Z.; Nakayama, Y.; Shiono, T. Synthesis of highly branched polyolefins using phenyl substituted α-diimine Ni (II) catalysts. Polymers 2016, 8, 160. [Google Scholar] [CrossRef]
- Xavier, A.; Srividhya, N. Synthesis and study of Schiff base ligands. IOSR J. Appl. Chem. 2014, 7, 6–15. [Google Scholar] [CrossRef]
- Popescu, V.; Muresan, E.I.; Grigoriu, A.M. Monochlorotriazinyl-cyclodextrin treating onto polyester fabrics and films. Carbohydr. Polym. 2011, 86, 600–611. [Google Scholar] [CrossRef]
- Popescu, V.; Sandu, I.C.A.; Popescu, G.; Popa, A.; Radu, C.D. Colorimetric answer of monochlorotriazinyl-β- cyclodextrin grafted onto PAN support chemical modified with NaOH and amines. Rev. Chim. 2015, 66, 1765–1771. [Google Scholar]
- Coates, J. Interpretation of infrared spectra, a practical approach. In Encyclopedia of Analytical Chemistry; Meyers, R.A., Ed.; John Wiley & Sons, Ltd.: Chichester, UK, 2000; pp. 10815–10837. [Google Scholar]
- French, A.D. Idealized powder diffraction patterns for cellulose polymorphs. Cellulose 2014, 21, 885–896. [Google Scholar] [CrossRef]
- French, A.D.; Cintron, S.M. Cellulose polymorphy, crystallite size, and the Segal Crystallinity Index. Cellulose 2013, 20, 583–588. [Google Scholar] [CrossRef]
- Agarwal, U.P.; Ralph, S.A.; Baez, C.; Reiner, R.S.; Verrill, S.P. Effect of sample moisture content on XRD-estimated cellulose crystallinity index and crystallite size. Cellulose 2017, 24, 1971–1984. [Google Scholar] [CrossRef]
- Iliescu, E.; Nagy, G.; Popescu, V. Superior Finishing of Textile Materials: Wrinkle- Proofing; Tehno Press: Iasi, Romania, 2004; Volume 1. [Google Scholar]
- Neto, C.G.T.; Giacometti, J.A.; Job, A.E.; Ferreira, F.C.; Fonseca, J.L.C.; Pereira, M.R. Thermal analysis of chitosan based networks. Carbohydr. Polym. 2005, 62, 97–103. [Google Scholar] [CrossRef]
- Naggar, M.E.; Shaarawy, S.; Shafie, A.E.l.; Hebeish, A. Development of antimicrobial medical cotton fabrics using synthesized nanoemulsion of reactive cyclodextrin hosted coconut oil inclusion complex. Fibers Polym. 2017, 18, 1486–1495. [Google Scholar] [CrossRef]
- Nayak, R.; Padhye, R. Antimicrobial finishes for textiles. In Functional Finishes for Textiles. Improving Comfort, Performance and Protection; Paul, R., Ed.; Woodhead Publishing: Cambridge, UK, 2015; pp. 361–385. [Google Scholar]
- Popescu, O.; Dunca, S.; Grigoriu, A. Antibacterial action of silver applied on cellulose fibers grafted with monochlorotriazinyl-β-cyclodextrin. Cellul. Chem. Technol. 2013, 47, 247–255. [Google Scholar]
- Rehan, M.; Naggar, M.E.; Mashaly, H.M.; Wilken, R. Nanocomposites based on chitosan/silver/clay for durable multi-functional properties of cotton fabrics. Carbohydr. Polym. 2018, 182, 29–41. [Google Scholar] [CrossRef]
- Naggar, M.E.; Shaarawy, S.; Hebeish, A.A. Bactericidal finishing of loomstate, scoured and bleached cotton fi-bresvia sustainable in-situ synthesis of silver nanoparticles. Int. J. Biol. Macromol. 2018, 106, 1192–1202. [Google Scholar] [CrossRef]
- Mohamed, A.L.; Naggar, M.E.; Shaheen, T.I.; Hassabo, A.G. Laminating of chemically modified silan based nano sols for advanced functionalization of cotton textiles. Int. J. Biol. Macromol. 2017, 95, 429–437. [Google Scholar] [CrossRef]
- Pasricha, A.; Jangra, S.L.; Singh, N.; Dilbaghi, N.; Sood, K.N.; Arora, K.; Pasricha, R. Comparative study of leaching of silver nanoparticles from fabric and effective effluent treatment. J. Environ. Sci. 2012, 24, 852–859. [Google Scholar] [CrossRef]

| Coding for X1, X2, X3 | Independent Variables (Real Values) | ||
|---|---|---|---|
| X1 (% Owf) | X2 (% Owf) | X3 (% Owf) | |
| −1.682 | 3 | 3 | 6 |
| −1 | 5.4 | 5.4 | 6.6 |
| 0 | 9 | 9 | 7.5 |
| +1 | 12.57 | 12.57 | 8.4 |
| +1.682 | 15 | 15 | 9 |
| X1 Code | X2 Code | X3 Code | D-CD Code | Code of Treated Sample |
|---|---|---|---|---|
| −1 | −1 | −1 | D1 | S1 |
| 1 | −1 | −1 | D2 | S2 |
| −1 | 1 | −1 | D3 | S3 |
| 1 | 1 | −1 | D4 | S4 |
| −1 | −1 | 1 | D5 | S5 |
| 1 | −1 | 1 | D6 | S6 |
| −1 | 1 | 1 | D7 | S7 |
| 1 | 1 | 1 | D8 | S8 |
| −1.682 | 0 | 0 | D9 | S9 |
| +1.682 | 0 | 0 | D10 | S10 |
| 0 | −1.682 | 0 | D11 | S11 |
| 0 | +1.682 | 0 | D12 | S12 |
| 0 | 0 | −1.682 | D13 | S13 |
| 0 | 0 | +1.682 | D14 | S14 |
| 0 | 0 | 0 | D15 | S15 |
| 0 | 0 | 0 | D16 | S16 |
| 0 | 0 | 0 | D17 | S17 |
| 0 | 0 | 0 | D18 | S18 |
| 0 | 0 | 0 | D19 | S19 |
| 0 | 0 | 0 | D20 | S20 |
| Sample Code | Element (% At) (By EDAX) | Element (% At) (By Computation) | ||||||
|---|---|---|---|---|---|---|---|---|
| C | O | N | Na | Cl a | N b | N c | Cl d | |
| Control | 54.62 | 45.38 | - | - | - | - | - | - |
| S5 | 39.97 | 48.38 | 9.46 | 1.66 | 0.53 | 7.74 | 1.72 | 1.13 |
| S14 | 34.05 | 54.04 | 9.79 | 1.89 | 0.22 | 8.01 | 1.78 | 1.67 |
| S15 | 34.10 | 55.17 | 9.59 | 0.98 | 0.17 | 7.85 | 1.74 | 0.81 |
| bi Coefficient (i = 1 ÷ 3) | Water Absorption Capacity | ||
|---|---|---|---|
| 5 min | 30 min | 60 min | |
| bo | 10.4044 | 16.2626 | 20.2586 |
| b1 | 0.0762 | 0.0822 | 0.2297 |
| b2 | 0.0192 | 0.2793 | 0.1710 |
| b3 | 0.1819 | 0.5274 | 0.5086 |
| b12 | −0.0750 | −0.0250 | −0.1875 |
| b13 | −0.0750 | −0.1500 | −0.2125 |
| b23 | 0.2250 | −0.2750 | 0.2125 |
| b11 | −0.4104 | −0.7210 | −1.4540 |
| b22 | −0.2337 | −0.4028 | −0.8884 |
| b33 | −0.3221 | −0.5796 | −1.1712 |
| WAC a | Stationary Points | |
|---|---|---|
| Codified Values | Real Values (% owf) | |
| WAC 5 | X1 = 0.1203 | X1 = 9.4291 |
| X2 = 0.1675 | X2 = 9.5875 | |
| X3 = 0.4678 | X3 = 7.9171 | |
| WAC 30 | X1 = 0.1533 | X1 = 9.5468 |
| X2 = 0.0247 | X2 = 9.0881 | |
| X3 = −0.9294 | X3 = 6.6711 | |
| WAC 60 | X1 = 0.16191 | X1 = 9.5777 |
| X2 = −0.0512 | X2 = 8.8173 | |
| X3 = −1.0901 | X3 = 6.5279 | |
| Sample Code | Treatment Conditions (Real Values) | IC Quality Index | |||
|---|---|---|---|---|---|
| X1 (% Owf) | X2 (% Owf) | X3 (% Owf) | (On Warp) | (On Weft) | |
| S1 | 5.4 | 5.4 | 6.6 | 1.14 | 1.01 |
| S2 | 12.57 | 5.4 | 6.6 | 1.41 | 1.42 |
| S3 | 5.4 | 12.57 | 6.6 | 1.37 | 1.46 |
| S4 | 12.57 | 12.57 | 6.6 | 1.19 | 1.41 |
| S5 | 5.4 | 5.4 | 8.4 | 1.25 | 1.16 |
| S6 | 12.57 | 5.4 | 8.4 | 1.09 | 1.23 |
| S7 | 5.4 | 12.57 | 8.4 | 1.07 | 1.35 |
| S8 | 12.57 | 12.57 | 8.4 | 1.07 | 1.39 |
| S9 | 3 | 9 | 7.5 | 1.01 | 1.49 |
| S10 | 15 | 9 | 7.5 | 1.06 | 1.17 |
| S11 | 9 | 3 | 7.5 | 1.26 | 1.01 |
| S12 | 9 | 15 | 7.5 | 1.03 | 1.04 |
| S13 | 9 | 9 | 6 | 1.00 | 1.00 |
| S14 | 9 | 9 | 9 | 1.03 | 1.07 |
| S15 | 9 | 9 | 7.5 | 1.04 | 1.01 |
| Sample | Diameter of Inhibition Zone (mm) | |||
|---|---|---|---|---|
| Escherichia coli DSMZ 498 | Micrococcus luteus ATCC 934 | |||
| Without AgNO3 | With AgNO3 | Without AgNO3 | With AgNO3 | |
| S4 | 0 | 17 | 17 | 18 |
| S4 washed 5 times | 0 | 0 | 0 | 17 |
| S4 washed 10 times | 0 | 0 | 0 | 16 |
| S8 | 0 | 18 | 19 | 20 |
| S8 washed 5 times | 0 | 17 | 0 | 18 |
| S8 washed 10 times | 0 | 0 | 0 | 16 |
| S11 | 0 | 17 | 16 | - |
| S11 washed 5 times | 0 | 16 | 0 | - |
| S11 washed 10 times | 0 | 0 | 0 | - |
| S12 | 0 | 16 | 19 | - |
| S12 washed 5 times | 0 | 0 | 0 | - |
Publisher’s Note: MDPI stays neutral with regard to jurisdictional claims in published maps and institutional affiliations. |
© 2021 by the authors. Licensee MDPI, Basel, Switzerland. This article is an open access article distributed under the terms and conditions of the Creative Commons Attribution (CC BY) license (http://creativecommons.org/licenses/by/4.0/).
Share and Cite
Popescu, V.; Petrea, M.; Popescu, A. Multifunctional Finishing of Cotton with Compounds Derived from MCT-β-CD and Quantification of Effects Using MLR Statistical Analysis. Polymers 2021, 13, 410. https://doi.org/10.3390/polym13030410
Popescu V, Petrea M, Popescu A. Multifunctional Finishing of Cotton with Compounds Derived from MCT-β-CD and Quantification of Effects Using MLR Statistical Analysis. Polymers. 2021; 13(3):410. https://doi.org/10.3390/polym13030410
Chicago/Turabian StylePopescu, Vasilica, Marioara Petrea, and Andrei Popescu. 2021. "Multifunctional Finishing of Cotton with Compounds Derived from MCT-β-CD and Quantification of Effects Using MLR Statistical Analysis" Polymers 13, no. 3: 410. https://doi.org/10.3390/polym13030410
APA StylePopescu, V., Petrea, M., & Popescu, A. (2021). Multifunctional Finishing of Cotton with Compounds Derived from MCT-β-CD and Quantification of Effects Using MLR Statistical Analysis. Polymers, 13(3), 410. https://doi.org/10.3390/polym13030410
